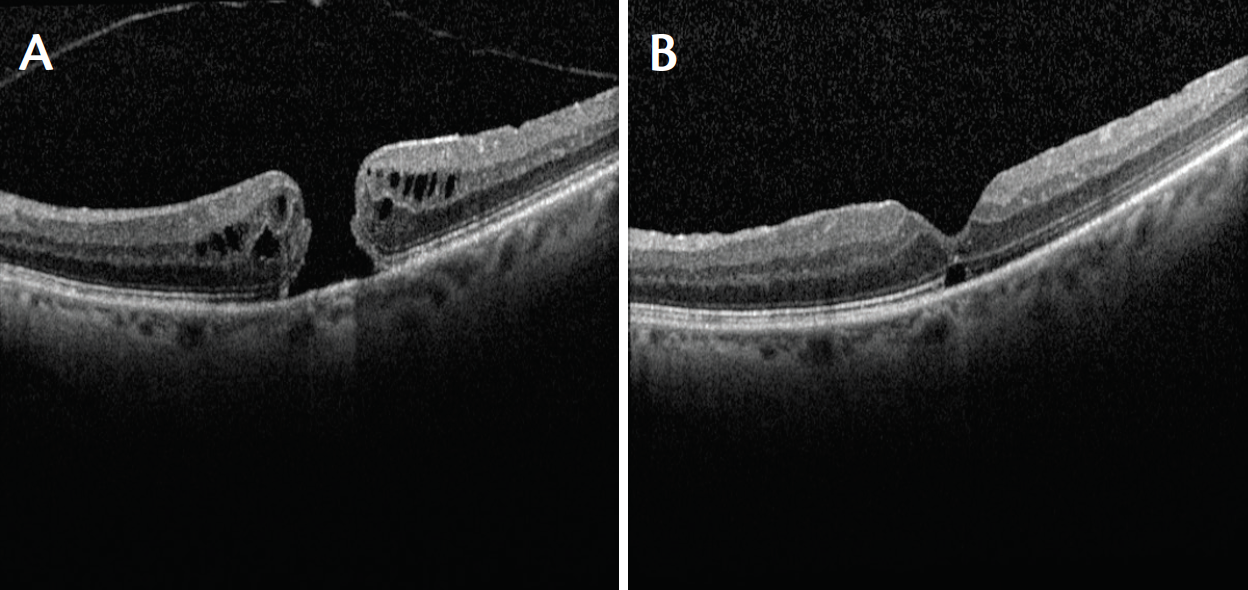
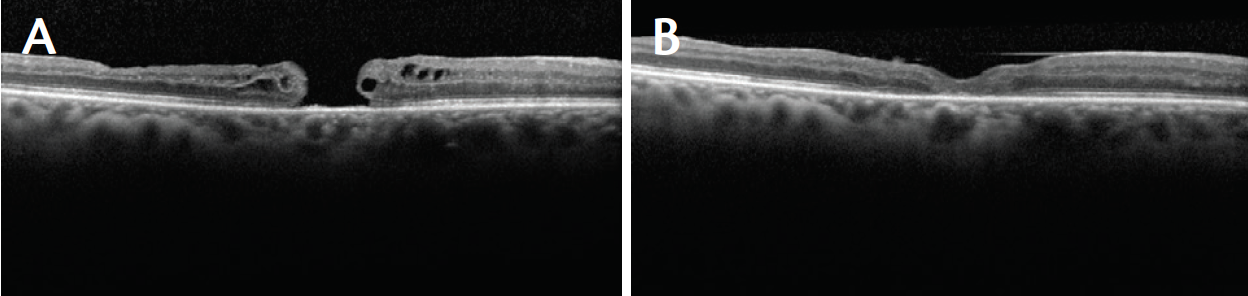
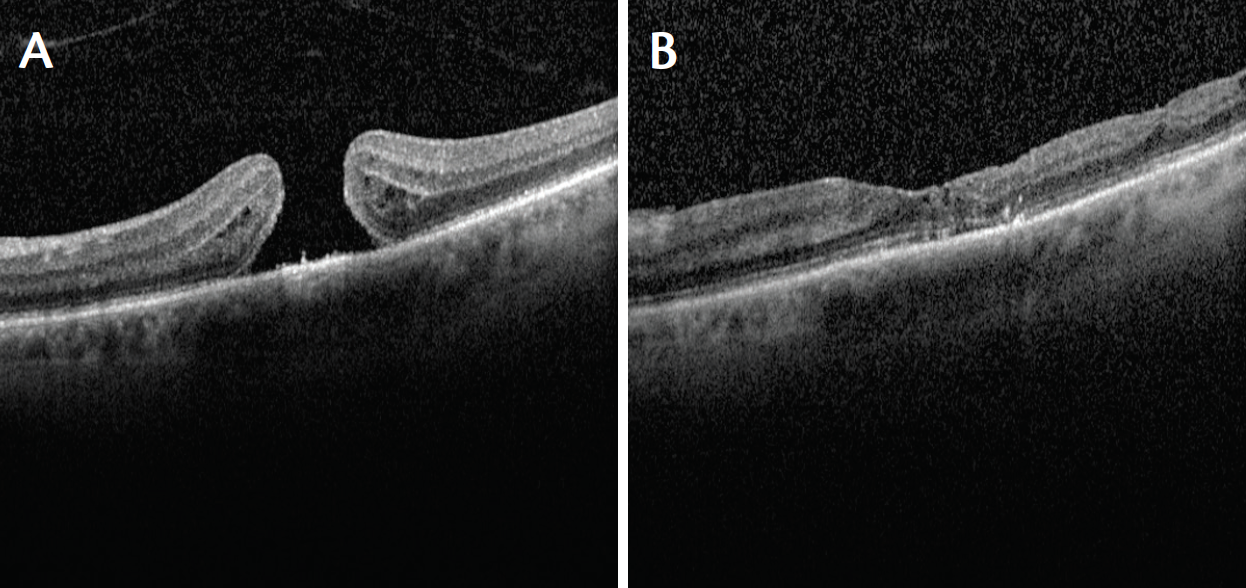

Macular hole repair is one of the most predictably successful surgical procedures for retina surgeons, with a single operation success rate in excess of 90%.1 Some macular holes, typically larger and more chronic holes, are more difficult to close. The International Vitreomacular Traction Study Group defined large macular holes as those more than 400 µm in diameter.2
AT A GLANCE
• Many large and chronic macular holes can be closed with conventional surgery, but some cannot.
• Macular holes that do not respond to initial standard repair may require additional surgical techniques, such as an ILM patch or inverted ILM flap.
• With an inverted ILM flap, the surgeon leaves a piece of ILM attached to the edge of the macular hole. The flap is inverted over the hole, leaving the hole covered after fluid-gas exchange to induce and support glial cell proliferation and lead ideally to hole closure.
• With an ILM patch, a small piece of peeled ILM is placed within the macular hole.
Kelly and Wendel, who first described macular hole surgery 25 years ago, felt that visual outcomes were better for holes present 6 months or less.3 Surgical success rates for closure of chronic macular holes vary. One series found a closure rate of 71% for holes present 2 years or more.4 Another series reported a closure rate of only 47% for holes present more than 1 year.1
While many large and chronic macular holes can be closed with conventional surgery—meaning vitrectomy, peeling of the internal limiting membrane (ILM), gas bubble, and optional positioning—a significant portion of them will not close. For these challenging cases, additional surgical techniques are needed. A technique was described in 2010 to address larger macular holes: the inverted ILM flap.5 Instead of completely peeling and removing the ILM from around the macular hole, the surgeon leaves a piece of ILM attached to the edge of the hole, and this flap is folded over the hole in an inverted manner to leave the hole covered after fluid-gas exchange. The theory is that the flap serves as a scaffold to induce and support glial cell proliferation, which leads to hole closure.5 I equate it to using a skin graft to facilitate closure of a chronic skin defect rather than waiting for the defect to slowly fill in over time.
In this article, I would like to expand on this concept by looking at the use of the ILM flap in two specific categories of macular hole: (1) large, chronic holes undergoing a first attempt at repair and (2) holes in which initial standard repair failed. Both can benefit from an ILM flap, the difference being whether it is a folded-over flap or a freestanding ILM patch.
MACULAR HOLE TYPES
The first category of macular hole describes surgery-naïve eyes that present with a large macular hole of long standing. I define large as a hole greater than 400 µm minimum width as measured with the caliper function on optical coherence tomography.3 Chronic holes are those present longer than 6 months based on history. For these eyes, I use an ILM flap. While many of these eyes can be successfully repaired with standard surgery, meaning no ILM flap, I believe adding this one extra step raises the success rate above 90%, similar to the success rate for smaller and more recent-onset holes.
The second category of macular hole describes eyes that have undergone previous macular hole surgery including ILM peeling, but for whatever reason the hole failed to close. Repeat surgery on these eyes necessitates an ILM patch using ILM distant from the macular hole, rather than a flap, because the ILM has already been peeled from immediately around the hole.
ILM FLAP TECHNIQUE
After the ILM is stained with the surgeon’s agent of choice (my preference is brilliant blue G), the ILM is peeled circumferentially around the hole, leaving a wedge-shaped piece of ILM attached to the temporal edge of the hole via a small pedicle. This leaves an attached flap of ILM that can be folded over the hole. One must be sure the peeling extends beyond the flap, ideally 1.5 disc diameters to 2 disc diameters from the fovea.
The loose ILM flap tends to scroll and is also quite mobile, flapping like a flag in the breeze due to fluid currents within the eye. Use of valved vitrectomy cannulas is essential to minimize fluid currents. If the folded-over ILM flap does not lie flat covering the hole, or if it scrolls, it can be useful to gently tuck the flap into the macular hole to secure the free end under the hole edge during fluid-air exchange. The exchange should be done slowly, keeping the vitrector or extrusion cannula away from the macula to avoid inadvertently aspirating the flap. Tilting the eye nasally and keeping the extrusion instrument toward the nasal side allows the air bubble to trap the flap in place during the final phases of fluid-air exchange.
The surgeon’s standard gas mixture completes the case, and the standard positioning regimen is advised. My preference is 25% SF6 gas. I ask patients to maintain a reading position (head tilted downward as if reading a book on their lap) for the rest of the day, with no specific positioning thereafter except to avoid sleeping flat on the back for the first week if the patient is pseudophakic or for the duration of the bubble if the patient is phakic.
ILM PATCH TECHNIQUE
Despite the high success rate for surgical macular hole closure, some holes remain open even after ILM peeling and gas tamponade. Because the ILM has already been peeled from around the edges of these holes, an ILM flap is not possible. An ILM patch can be used as an alternative in a secondary surgery.
In these eyes I stain the ILM again to be sure it was ILM that was peeled, rather than an epiretinal membrane. This is especially important if I did not perform the initial surgery. Assuming a good initial ILM peel, I identify and peel a piece of ILM distant from the hole. A piece about 2 disc areas in size is adequate. The loose piece of ILM is gently placed within the hole, and the patch is tucked under the hole edges to keep it in place. Just like an ILM flap, the ILM patch tends to scroll. The tube shape of the ILM flap makes it easier to place into the hole. Simply placing the ILM patch over the hole will not work, as it will float away. Care must be taken not to disturb the underlying retinal pigment epithelium in the base of the hole during patch placement and manipulation.
Fluid-air exchange is performed as described above. Choice of tamponade is more difficult. Although gas can be used, my preference in these cases is for silicone oil. These are eyes that underwent previous standard surgery with ILM peeling and gas, yet the hole did not close. My assumption is that, for whatever reason, these eyes may require a longer-term tamponade; hence, my preference for silicone oil.
CASE STUDIES
Case No. 1
A 68-year-old woman presented with a macular hole of 1 month’s duration. Her visual acuity in the affected eye was 20/80, and the hole was slightly more than 400 µm in width (Figure 1A). She underwent vitrectomy with an ILM flap folded over the hole. At 3 months after surgery, the macular hole was closed, a small ellipsoid zone defect was present, and the patient’s visual acuity was 20/30 (Figure 1B).
Figure 1. Case No. 1: Macular hole of 1 month’s duration with diameter of slightly more than 400 μm (A). Visual acuity 20/80. Patient underwent vitrectomy with ILM flap folded over the hole. At 3 months after surgery, the macular hole was closed, a small ellipsoid zone defect was present, and visual acuity was 20/30 (B).
Case No. 2
A 68-year-old man underwent macular hole repair elsewhere 4 years before presentation to my center. The hole was open and 500 µm in width. The patient’s visual acuity in the affected eye was 20/250 (Figure 2A). He underwent vitrectomy with an ILM patch and silicone oil placement. At 2 weeks after surgery, the hole was closed, and the patient’s visual acuity had improved to 20/200 with noticeable subjective improvement in vision (Figure 2B).
Figure 2. Case No. 2: Open macular hole, 500 μm in width, despite repair surgery elsewhere 4 years earlier (A). Visual acuity 20/250. Patient underwent vitrectomy with ILM patch and silicone oil tamponade. At 2 weeks after surgery, the hole was closed, and visual acuity had improved to 20/200 with noticeable subjective improvement (B).
Case No. 3
A 68-year-old-man underwent macular hole repair with vitrectomy, ILM peeling, and gas tamponade. The hole did not close, and visual acuity in the affected eye was 20/200 (Figure 3A). The patient underwent repeat vitrectomy with an ILM patch and silicone oil tamponade. The hole closed, and his visual acuity had improved to 20/80 at 4 months after surgery and after silicone oil removal (Figure 3B).
Figure 3. Case No. 3: Open macular hole despite previous surgical repair. Visual acuity 20/200 (A). Patient underwent repeat vitrectomy with ILM patch and silicone oil tamponade. The hole closed, and visual acuity improved to 20/80 at 4 months after surgery and after silicone oil removal (B).
CONCLUSION
Using an ILM flap or patch provides surgeons with another option for initial repair of large chronic holes or for secondary surgery in macular holes that did not respond to initial standard repair. Although manipulating a small, mobile piece of ILM can be challenging, this technique may allow surgeons to salvage eyes in which standard macular hole repair would otherwise fail. n
1. Jaycock PD, Bunce C, Xing W, et al. Outcomes of macular hole surgery: implications for surgical management and clinical governance. Eye (Lond). 2005;19(8):849-884.
2. Duker JS, Kaiser PK, Binder S, et al. The International Vitreomacular Traction Study Group classification of vitreomacular adhesion, traction, and macular hole. Ophthalmology. 2013;120(12):2611-2619.
3. Kelly NE, Wendel RT. Vitreous surgery for idiopathic macular holes: results of a pilot study. Arch Ophthalmol. 1991;109(5):654-659.
4. Thompson JT, Sjaarda RN, Lansing MB. The results of vitreous surgery for chronic macular holes. Retina. 1997;17(6):493-501.
5. Michalewska Z, Michalewski J, Adelman RA, Nawrocki J. Inverted internal limiting membrane flap technique for large macular holes. Ophthalmology. 2010;117(10):2018-2025.
Section Editor Dean Eliott, MD
• associate director, retina service, Massachusetts Eye and Ear Infirmary, Boston, Mass.
Section Editor Ingrid U. Scott, MD, MPH
• professor of ophthalmology and public health sciences, Penn State Hershey Eye Center, Hershey, Pa.
Brian C. Joondeph, MD, MPS
• a partner at Colorado Retina Associates, Denver
• financial disclosure: speaker and consultant for DORC
• @retinaldoctor; bjoondeph@retinacolorado.com
























